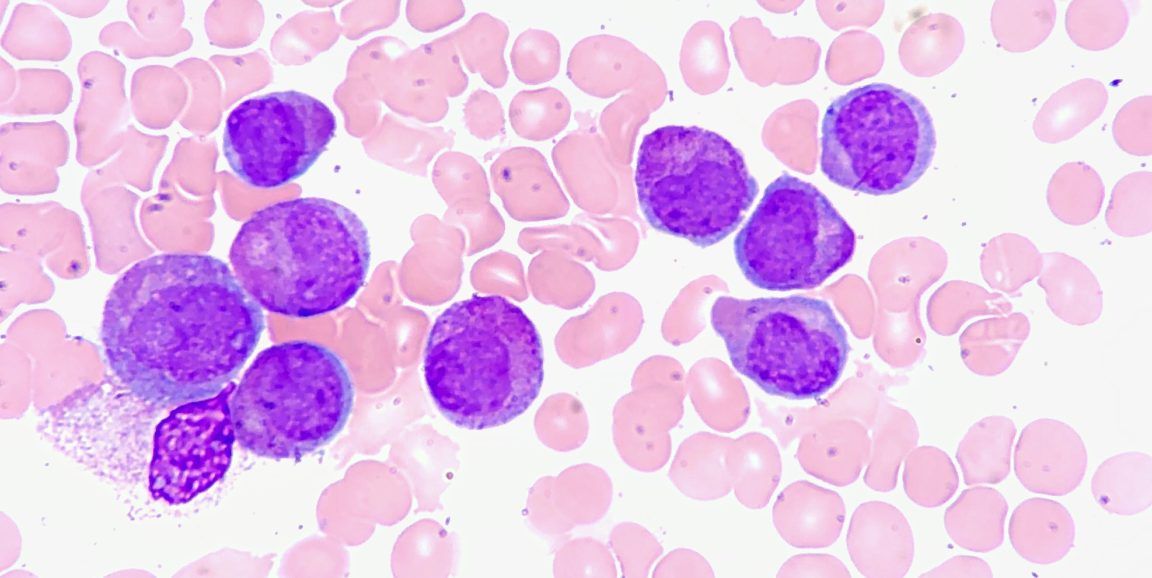
RosaQSP's tweet image. Computer models show promise for personalizing chemotherapy: buff.ly/2M9vHFe

#chemotherapy #stanford #computermodels #Cancer #personalizedmedicine

#computermodels Suchergebnisse
#ComputerModels Training Wales - we are the largest supplier of independent computer training in South #Wales. We also offer over three hundred #IT and #engineering courses. #Cardiff #Swansea #Bridgend #Newport computertrainingwales.co.uk

As part of our #NAMSeries, today we look at the non-animal method, "read-across", which predicts a new substance's #safety by comparing it to similar substances. It often uses #computermodels to find like-substances and existing data, helping to reduce #animaltesting. 🧬💻

Animal tests are unethical, but also proven ineffective b/c animals respond differently than humans when exposed to same #chemicals. 👎 In contrast #animalfree methods like human cell-based tests & #computermodels can deliver results to more accurately predict human responses.🧬

Just admit it... You #ClimateScientists don’t have a clue why we have #IceAges (and Little Ice Ages) and then Warming to melt the Ice. You have lots of theories. And lots of #ComputerModels ... But let’s spend $94 TRILLION.

Big news! A study has shown that complex #ComputerModels can be replaced with computationally-inexpensive #MachineLearning surrogates, and that these emulators can also provide essential components within future #DigitalTwin applications, find out more: pml.ac.uk/News/Predictin…
#brainimaging #brainhealth #computermodels #neuroimaging #computationalneuroscience @zuckermanbrain @nimhgov rfr.bz/t8bq93

#computermodels predict fake course of we earthlings, we are on cusp of Great Leap Forward, from #BigBang to #Solarsystem to #evolution of #cellularlife on bipedal sentience within 10,000 years of #Jericho we are measuring ripples in #spacetime #gravitationwaves #1_10000protondia

Relevant timescales for understanding climate and the building blocks: #oceanobservations, #computermodels and #climateservices across three projects @BG10Blueaction @TRIATLASproject @MISSIONATLANTIC

Can #ComputerModels of the #brain pave the way to cost-effective #drug discovery? Prof. V. Srinivasa Chakravarthy, Dept of #Biotechnology, @iitmadras, writes for BioSpectrum India Magazine (@BSI_social)

Here's another sampling of the #ComputerModels to see how consistent they are with #SnowTotals. RPM, NAM, GFS, and Euro are fairly similar to each other. Widespread 3-6 inch totals for most of N TX (and #DFW). Heavier amounts NW and SE of DFW. #dfwwx #NBCDFWWeather #WinterStorm




Meet David Walters, the head of the R2O team in #WeatherScience, who works with #computermodels to diagnose issues, coordinate improvements & evaluate their performance Watch this video to learn about his role! bit.ly/3ahBTW0
How can we build #ComputerModels about contradicting views, considering #narratives of groups that are pro and contra? #SystemsModeling #SocialImpact conference @tudelft in #TheHague #SISIG19 #SystemDynamics #SystemsThinking #agentbased #complexity @S_D_Society @WPISDclub

Computer models show promise for personalizing chemotherapy: buff.ly/2M9vHFe #chemotherapy #stanford #computermodels #Cancer #personalizedmedicine
Outreach today at equine table top sale and dog show in aid of Love Underdogs rescue. Fund the billboard campaign #computermodels #AI #Tox21 #UKBioBank #inChemico #StemCells #ModernScience #theprocessofanimaltestinghasneverbeenscientificallyvalidated @CBUK10 @CBUK22 @ArtCBUK

Three different #ComputerModels are all trending toward the same thing ... FINALLY some cooler air. That's the good news. The bad news is it's still about a week away. Hang in there ... it won't be too much longer! #BringOnFall #dfwwx #NBCDFWWeather



NASA-enabled AI Predictions May Give Time to Prepare for Solar Storms - technology.org/2023/04/05/nas… #ArtificialIntelligence #ComputerModels #MachineLearning #SolarStorm #SolarSystem #SolarWind #SpaceWeather

Neil Ferguson talking about Herd Immunity is dangerous pseudoscience, this covidiot must not be allowed to share his dangerous conspiracy theories. Please #FollowTheLatestScience not #computermodels thetimes.co.uk/article/neil-f…

🤔 💭 🤔 #weather #climatechange 🤡 🤡 🤡 When #ComputerModels Are #Flawed. #From 2013, #Satire or #Playbook? facebook.com/reel/840557225… ~IJ]
Computer models are game changers for serious bettors. Covers dropping next-level NFL predictive tech that'll give sharp players an instant edge across ALL bet types. #NFLBetting #ComputerModels #SportsBetting
Did you know our computer model now predicts the final score of every NFL game? Now you can always have an edge on game day whether you're betting the moneyline, spread, total, or player props 📊✅ Find it all on here ⤵️ 🔗: covers.com/sport/football…


Using Logic Circuits to Carry out a Logical Task. Logic circuits are the fundamental building blocks of computers, enabling them to perform an array of logical tasks Find more: youtu.be/1jTJJ0RvQuA #logiccircuits #computingfundamentals #computermodels #paradigmsofcomputation

𝐑𝐞𝐬𝐞𝐚𝐫𝐜𝐡 𝐂𝐡𝐚𝐥𝐥𝐞𝐧𝐠𝐞𝐬 𝐟𝐨𝐫 𝐋𝐚𝐫𝐠𝐞 𝐏𝐫𝐞𝐭𝐫𝐚𝐢𝐧𝐞𝐝 𝐌𝐨𝐝𝐞𝐥𝐬 Check out this past featured webinar! 🔍 buff.ly/cXekD6X #computermodels #modelingandsimulation #multimodal #multimodallearning #artificialintelligence #ai #usarmy #usnavy #usaf

Seminal review article on #pandemic mitigation measures (2006): brownstone.org/wp-content/upl… #ComputerModels "cannot be more than an ancillary aid in deciding policy," and #lockdowns are "ineffective and impractical," per the WHO, and "should be eliminated from serious consideration"
Scientists Reveal How They Build Computer Models! #ComputerModels #ScienceExplained #ResearchLab #ProteinAnalysis #XRayTechniques #DataDriven #ScientificDiscovery #Simulation #Innovation #DigitalModels
An exciting new publication from scientists at @KBI_UHN @KCNhub! 🧠🌟 See how Drs. Skinner and Lefebvre and their team harnessed powerful #computermodels to understand how the brain's #memory centre keeps its rhythms in sync to prevent neurological disease!
📖✨Congratulations to Dr. Frances Skinner, Krembil Emerita Scientist, and Dr. Jérémie Lefebvre, Krembil Affiliate Scientist from the @KCNhub, for their recent study published in Network Neuroscience! 🔗: linktr.ee/krembil




Meet Dr Sevrine Sailley, who uses #ComputerModels to estimate how #MarineEcosystems may change in the #future, to help society make more informed decisions in the #now. From estimating future #FishBiomass, to future #SeaTurtle #migration, read her story🔗pml.ac.uk/news/staff-spo…

#climatemodels #computermodels #modeling #climatemodeling #JamesHansen #zerohour #extremeweather #netzero #canbill #globalwarming #nasa x.com/JunkScience/st…
26 years ago today: NASA climate chief and Climate Hoax Patient Zero James Hansen admits that climate models don't work because the forces that drive climate change are not understood with sufficient accuracy. He admitted the his own model was wrong and that climate modeling is…

❗️❗️❗️❗️ #ClimateChange #ComputerModels
English botanist David Bellamy lost his job at the BBC after rejecting the man-made climate change narrative as "poppycock." Interviewer: "Do you believe man-made climate change is happening?" Bellamy: "Absolutely not... There is no actual proof. There are a whole series of…
With #AI #3D #COMPUTERMODELS and so on. Do #MEDSCHOOLS still need #CADAVERS. Just asking for my son 🤔
🚀 In this 1-minute #video, produced by @VPH_Institute & @KU_Leuven, you will discover how the #InSole solution uses advanced #ComputerModels simulations to achieve #insoles better personalisation, performance & correction! #InSilicoWorld YouTube 🎥 youtu.be/eHqMdGJsyps
Up next, @KBI_UHN Scientist Dr. Milad Lankarany (@MLankarany) explains how math can shed light on neurological conditions and his research using #AI and #ComputerModels 🖥️🧠

Michael Demkowicz also worked on this (@SandiaLabs & @TAMU) study, using updated #ComputerModels to show that his decade-old theories about metal's self-healing behavior at the nanoscale matched what was happening here. #MaterialsScience #SelfHealing #Metals
Join CSIAC on Aug. 14, at 12:00 PM EDT for a live webinar on “Research Challenges for Large Pretrained Models.” 👉 Register here: buff.ly/46qYI88. #computermodels #modelingandsimulation #multimodal #multimodallearning #artificialintelligence #ai #usarmy #usnavy #usaf

Join CSIAC on Aug. 14, at 12:00 PM EDT for a live webinar on “Research Challenges for Large Pretrained Models.” 👉 Register here: buff.ly/46qYI88. #computermodels #modelingandsimulation #multimodal #multimodallearning #artificialintelligence #ai #usarmy #usnavy #usaf
#ComputerModels Training Wales - we are the largest supplier of independent computer training in South #Wales. We also offer over three hundred #IT and #engineering courses. #Cardiff #Swansea #Bridgend #Newport computertrainingwales.co.uk

Suggest the @abcnewsPerth @ABCNews24 show the real temp data & show failures of #computermodels they r not #science

#brainimaging #brainhealth #computermodels #neuroimaging #computationalneuroscience @zuckermanbrain @nimhgov rfr.bz/t8bq93

As part of our #NAMSeries, today we look at the non-animal method, "read-across", which predicts a new substance's #safety by comparing it to similar substances. It often uses #computermodels to find like-substances and existing data, helping to reduce #animaltesting. 🧬💻

Animal tests are unethical, but also proven ineffective b/c animals respond differently than humans when exposed to same #chemicals. 👎 In contrast #animalfree methods like human cell-based tests & #computermodels can deliver results to more accurately predict human responses.🧬

Just admit it... You #ClimateScientists don’t have a clue why we have #IceAges (and Little Ice Ages) and then Warming to melt the Ice. You have lots of theories. And lots of #ComputerModels ... But let’s spend $94 TRILLION.

#HurricaneMatthew from ots solutions just a few hours ago to monster storm along the coast, #computermodels change

#ComputerModels help researchers discover that sinlge #aminoacid variations cause bigger changes than was known buff.ly/2sRZ3zT

6,700 new #computermodels of #cancer based on real patients are now available online through @biomodels & @emblebi. babraham.ac.uk/news/2017/08/o…

Can #ComputerModels of the #brain pave the way to cost-effective #drug discovery? Prof. V. Srinivasa Chakravarthy, Dept of #Biotechnology, @iitmadras, writes for BioSpectrum India Magazine (@BSI_social)

Outreaching in Camarthen today. Commitment to end animal testing enormous #computermodels #AI #Tox21 #UKBioBank #inChemico #StemCells #MicoDosing #MHRA #Toxicity #OrganOnAChip #HumanTissue #Organoids #VirtualScreening #InVitro #InSilico #MedicalImaging @CBUK10 @CBUK22

Outreach today at equine table top sale and dog show in aid of Love Underdogs rescue. Fund the billboard campaign #computermodels #AI #Tox21 #UKBioBank #inChemico #StemCells #ModernScience #theprocessofanimaltestinghasneverbeenscientificallyvalidated @CBUK10 @CBUK22 @ArtCBUK

Climate Models Can’t Even ... peterdegedo.com/2017/09/17/cli… #AtmosphericPressure #ClimateChange #ComputerModels #DrTimBall #GavinSchmidt C ...

#ComputerModels help researchers discover that sinlge #aminoacid variations cause bigger changes than was known buff.ly/2sS8Juo

.@NASA is Building #ComputerModels of Possible #Asteroid #ImpactScenarios - @SpaceDailyCom: bit.ly/2uyKq1U

Something went wrong.
Something went wrong.
United States Trends
- 1. Good Thursday 30.4K posts
- 2. #thursdayvibes 1,903 posts
- 3. Merry Christmas 68.3K posts
- 4. Happy Friday Eve N/A
- 5. #JASPER_TouchMV 241K posts
- 6. DataHaven 11.6K posts
- 7. #NationalCookieDay N/A
- 8. JASPER COMEBACK TOUCH 157K posts
- 9. #ThursdayThoughts 1,436 posts
- 10. Hilux 8,484 posts
- 11. #thursdaymotivation 2,339 posts
- 12. Toyota 28.8K posts
- 13. Earl Campbell 2,444 posts
- 14. Omar 187K posts
- 15. The Grinch 10.8K posts
- 16. Colbert 4,484 posts
- 17. Prince Harry 9,414 posts
- 18. Halle Berry 4,287 posts
- 19. Happy Birthday Dan 1,756 posts
- 20. Steve Cropper 8,856 posts

















































